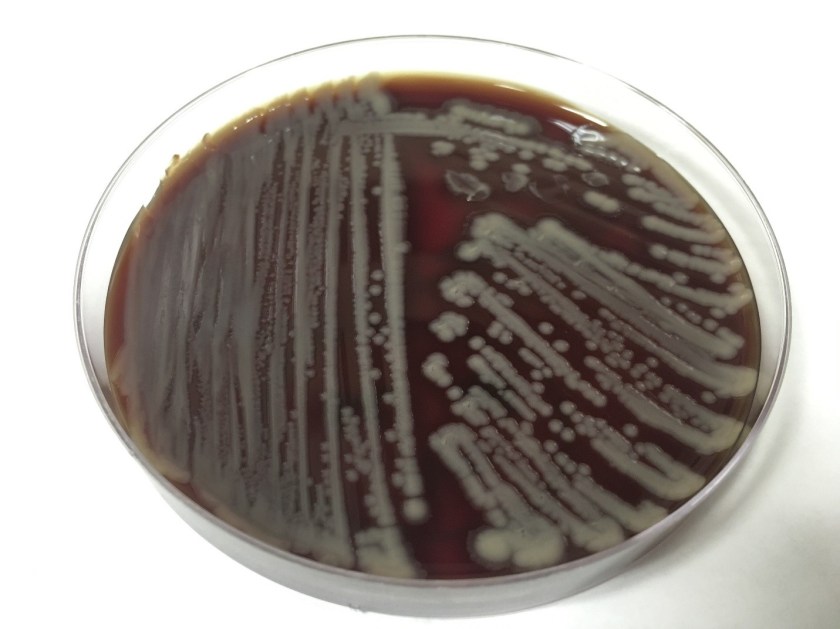
vibalg

Case History
A young adult female presents to an urgent care clinic with the chief complaint of a “bump and surrounding redness” on her right medial thigh. The patient reports the bump had been present without change for 1 year. Approximately 2 days prior to presenting at the urgent care clinic the patient states she nicked the bump while shaving, and subsequently the bump became tender with surrounding erythema and produced purulent drainage. The patient denies any similar prior lesions and denies any significant past medical history. On physical exam, the lesion measured 1 cm with the surrounding erythema measuring 5cm. The urgent care physician performed an incision and drainage and noted a scant amount of white purulent material within the lesion. A cyst wall was identified and was removed as much as possible. A swab of the purulent material was collected and submitted to microbiology for culture.
Laboratory Identification
The primary gram smear of the swab specimen was interpreted as no bacteria or polys seen. Routine culture media including blood, chocolate, MacConkey, and CNA agar were inoculated and incubated aerobically. Following incubation, the blood agar showed few gram positive cocci consistent with usual skin flora and few single morphology of medium to large sized gray colonies without hemolysis. On the MacConkey agar, few single morphology non-lactose fermenting colonies were identified. The gray colonies identified on the blood agar gram stained as gram negative bacilli with unremarkable morphology. An oxidase test was performed and the bacteria was found to be oxidase positive. The key biochemical and physiologic characteristics of the isolate included: good growth on thiosulfate citrate bile salts and sucrose (TCBS) agar with yellow colonies, good growth in 6% NaCl nutrient broth, and no growth in 0% NaCl nutrient broth. The organism was identified by matrix-assisted laser desorption/ionization time of flight (MALDI-TOF) as Vibrio alginolyticus.

Discussion
Vibrio spp. are water organisms commonly found in marine or brackish water environments. These organisms are gram negative bacilli which classically have “comma” shaped morphology on gram smear, though this is not an absolute. On sheep blood agar, these organisms are variably beta hemolytic medium to large gray colonies and on MacConkey agar are non-lactose fermenting (with the exception of Vibrio vulnificus). Vibrio spp. are oxidase positive, ferment glucose, and readily grow on most isolation media with growth being enhanced with the addition of 1% NaCl to the media. The growth characteristics on media containing different concentrations of NaCl can be used in differentiating the different Vibrio spp. Thiosulfate Citrate Bile Salts and Sucrose (TCBS) agar is both selective and differential for Vibrio spp. with sucrose fermentation being detected as yellow colony formation.
Vibrio angiolyticus typically causes extraintestinal infections, with wound infections and otitis externa being the most frequent. Transmission frequently occurs via traumatic aquatic injuries in contaminated water. Vibrio angiolyticus rarely causes intestinal disease and is isolated in less than 5% of stool cultures in patients with Vibrio associated diarrhea. Growth characteristics of Vibrio alginolyticus include yellow colonies on TCBS due to its ability to ferment sucrose and good growth on 6% NaCl and no growth on 0% NaCl. Additional key biochemical characteristics of Vibrio alginolyticus include oxidase positivity, nitrite positivity, negative for myo-Inositol fermentation, negative for arginine dihydrolase, positive for lysine decarboxylase, and variable positivity for ornithine decarboxylase. Most wound infections due to Vibrio alginolyticus are non-severe, and most mild infections will clear without antibiotic therapy.
References
- Procop GW, Koneman EW. Koneman’s Color Atlas and Textbook of Diagnostic Microbiology, North American Edition. LWW; 2016.
- Morris, J., Calderwodd, S., and Bloom, A. Minor Vibrio and Vibrio-like species associated with human disease. In: UpToDate, Post, TW (Ed), UpToDate, Waltham, MA, 2017.
-Justin Rueckert, DO is a 3nd year anatomic and clinical pathology resident at the University of Vermont Medical Center.

-Christi Wojewoda, MD, is the Director of Clinical Microbiology at the University of Vermont Medical Center and an Associate Professor at the University of Vermont.